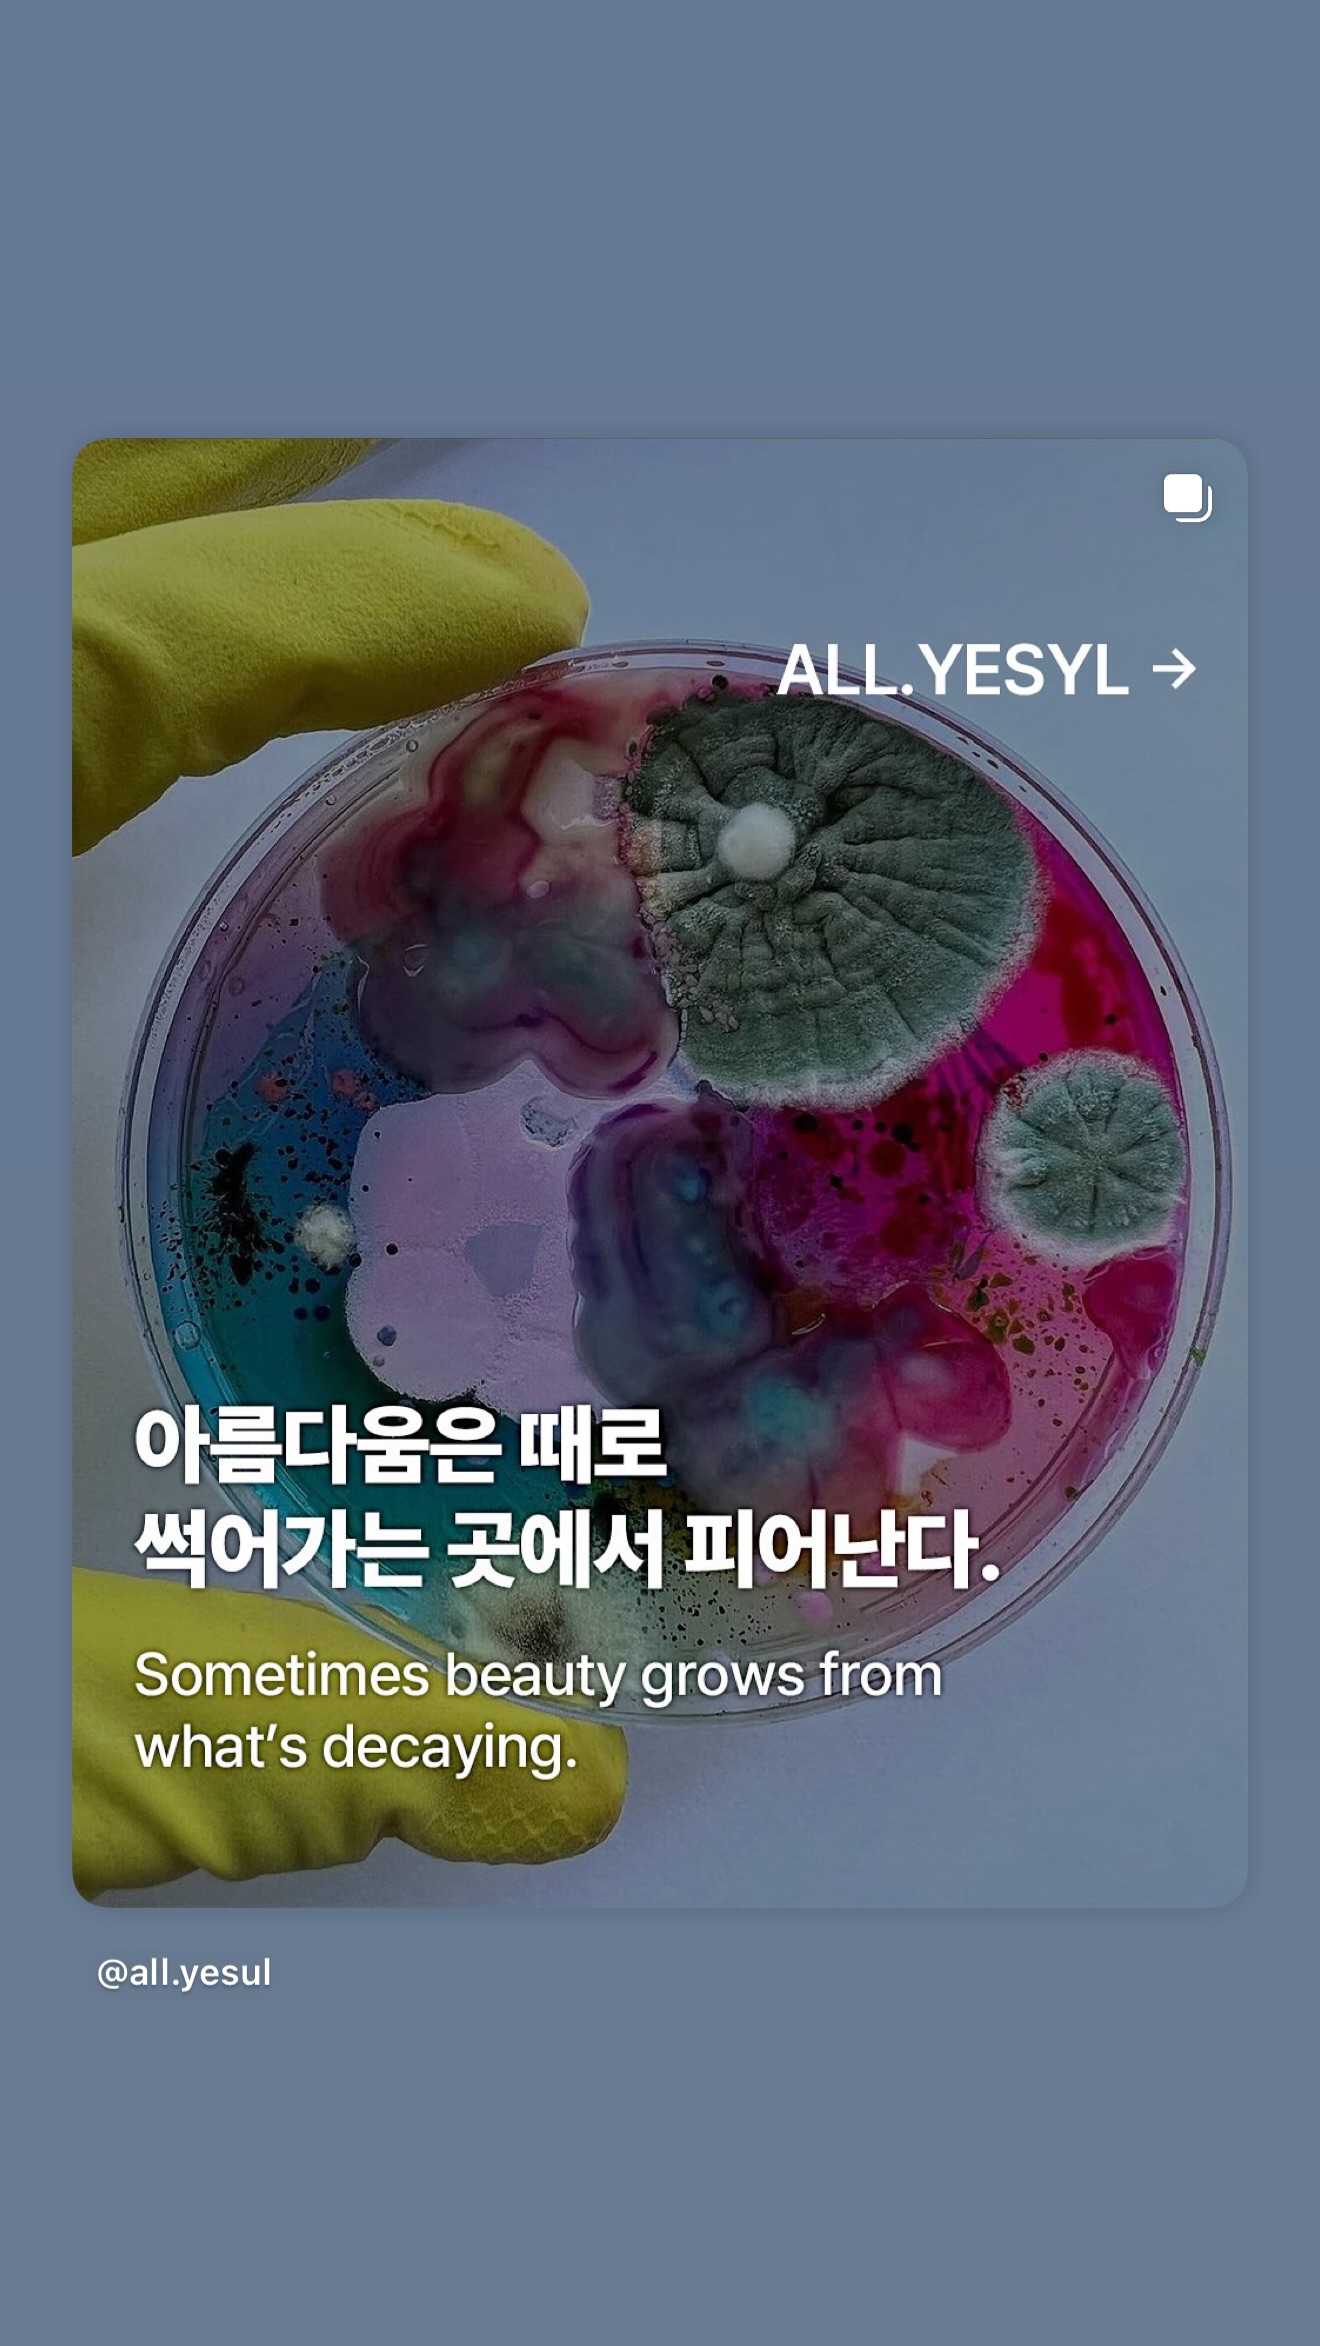
Bsgufb

|
이벤트 공지
|
|
[선정 시 최대 100만원] 커뮤니티 하는 누구나, 네이버 라운지의 메이트가 되어보세요!
237 |
12.26 |
21,386 |
|
공지
|
|
[공지] 언금 공지 해제
|
24.12.06 |
4,369,969 |
|
공지
|
|
📢📢【매우중요】 비밀번호❗❗❗❗ 변경❗❗❗ 권장 (현재 팝업 알림중)
|
24.04.09 |
11,088,594 |
|
공지
|
|
공지가 길다면 한번씩 눌러서 읽어주시면 됩니다.
|
23.11.01 |
12,411,672 |
|
공지
|
|
◤더쿠 이용 규칙◢ [스퀘어 정치글은 정치 카테고리에]
|
20.04.29 |
34,410,895 |
|
공지
|
알림/결과 |
𝑾𝑬𝑳𝑪𝑶𝑴𝑬 𝑻𝑶 𝑴𝒀 𝑹𝑶𝑶𝑴 🏁 제방 인구조사
148 |
22.01.27 |
15,876 |
|
공지
|
알림/결과 |
𝑾𝑬𝑳𝑪𝑶𝑴𝑬 𝑻𝑶 𝑴𝒀 𝑹𝑶𝑶𝑴 🏁 제방 정리글
19 |
22.01.27 |
17,098 |
| 모든 공지 확인하기() |
|
59259 |
스퀘어 |
251227 노제 인스스
1 |
12.27 |
11 |
|
59258 |
스퀘어 |
리정 인스타 릴스 노제
2 |
12.27 |
17 |
|
59257 |
잡담 |
지혜시💙
|
12.27 |
9 |
|
59256 |
잡담 |
졔모닝💙
|
12.27 |
15 |
|
59255 |
잡담 |
졔모닝💙
|
12.26 |
5 |
|
59254 |
스퀘어 |
효진초이 인스타 노제
1 |
12.25 |
22 |
|
59253 |
스퀘어 |
ExtraL / Special Workshop / @BUMSUP
1 |
12.25 |
20 |
|
59252 |
잡담 |
지혜시💙
|
12.25 |
12 |
|
59251 |
잡담 |
졔모닝💙
|
12.25 |
9 |
|
59250 |
잡담 |
룸메들 메리 크리스마스💙🎄
2 |
12.25 |
20 |
|
59249 |
스퀘어 |
지혜 버블 새 프사
2 |
12.24 |
224 |
|
59248 |
잡담 |
졔모닝💙
|
12.24 |
13 |
|
59247 |
스퀘어 |
251223 노제 인스스
1 |
12.23 |
291 |
|
59246 |
잡담 |
졔모닝💙
|
12.23 |
12 |
|
59245 |
스퀘어 |
251222 노제 인스스
1 |
12.23 |
342 |
|
59244 |
잡담 |
졔모닝💙
|
12.22 |
19 |
|
59243 |
잡담 |
지혜시💙
|
12.21 |
11 |
|
59242 |
잡담 |
졔모닝💙
|
12.21 |
35 |
|
59241 |
잡담 |
지혜시💙
|
12.20 |
39 |
|
59240 |
잡담 |
졔모닝💙
|
12.20 |
66 |